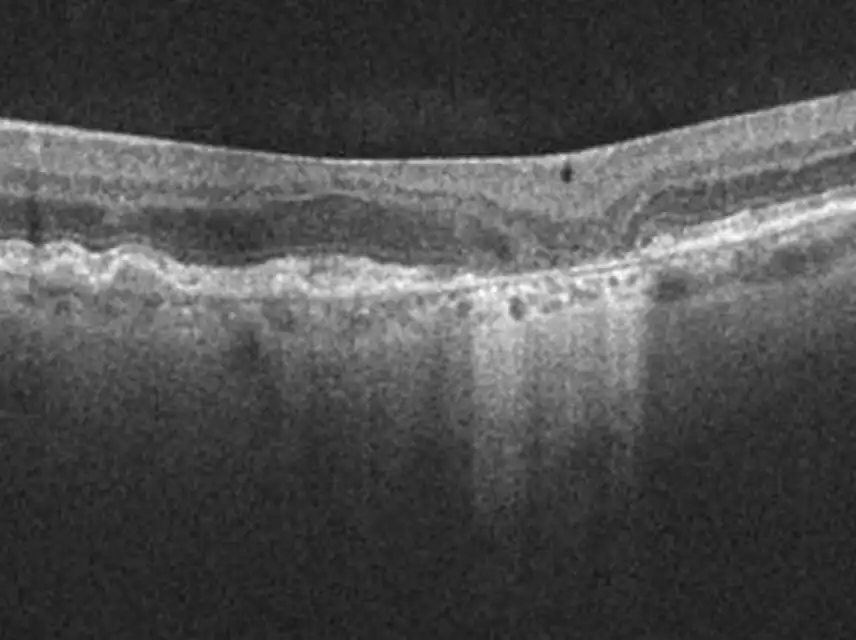
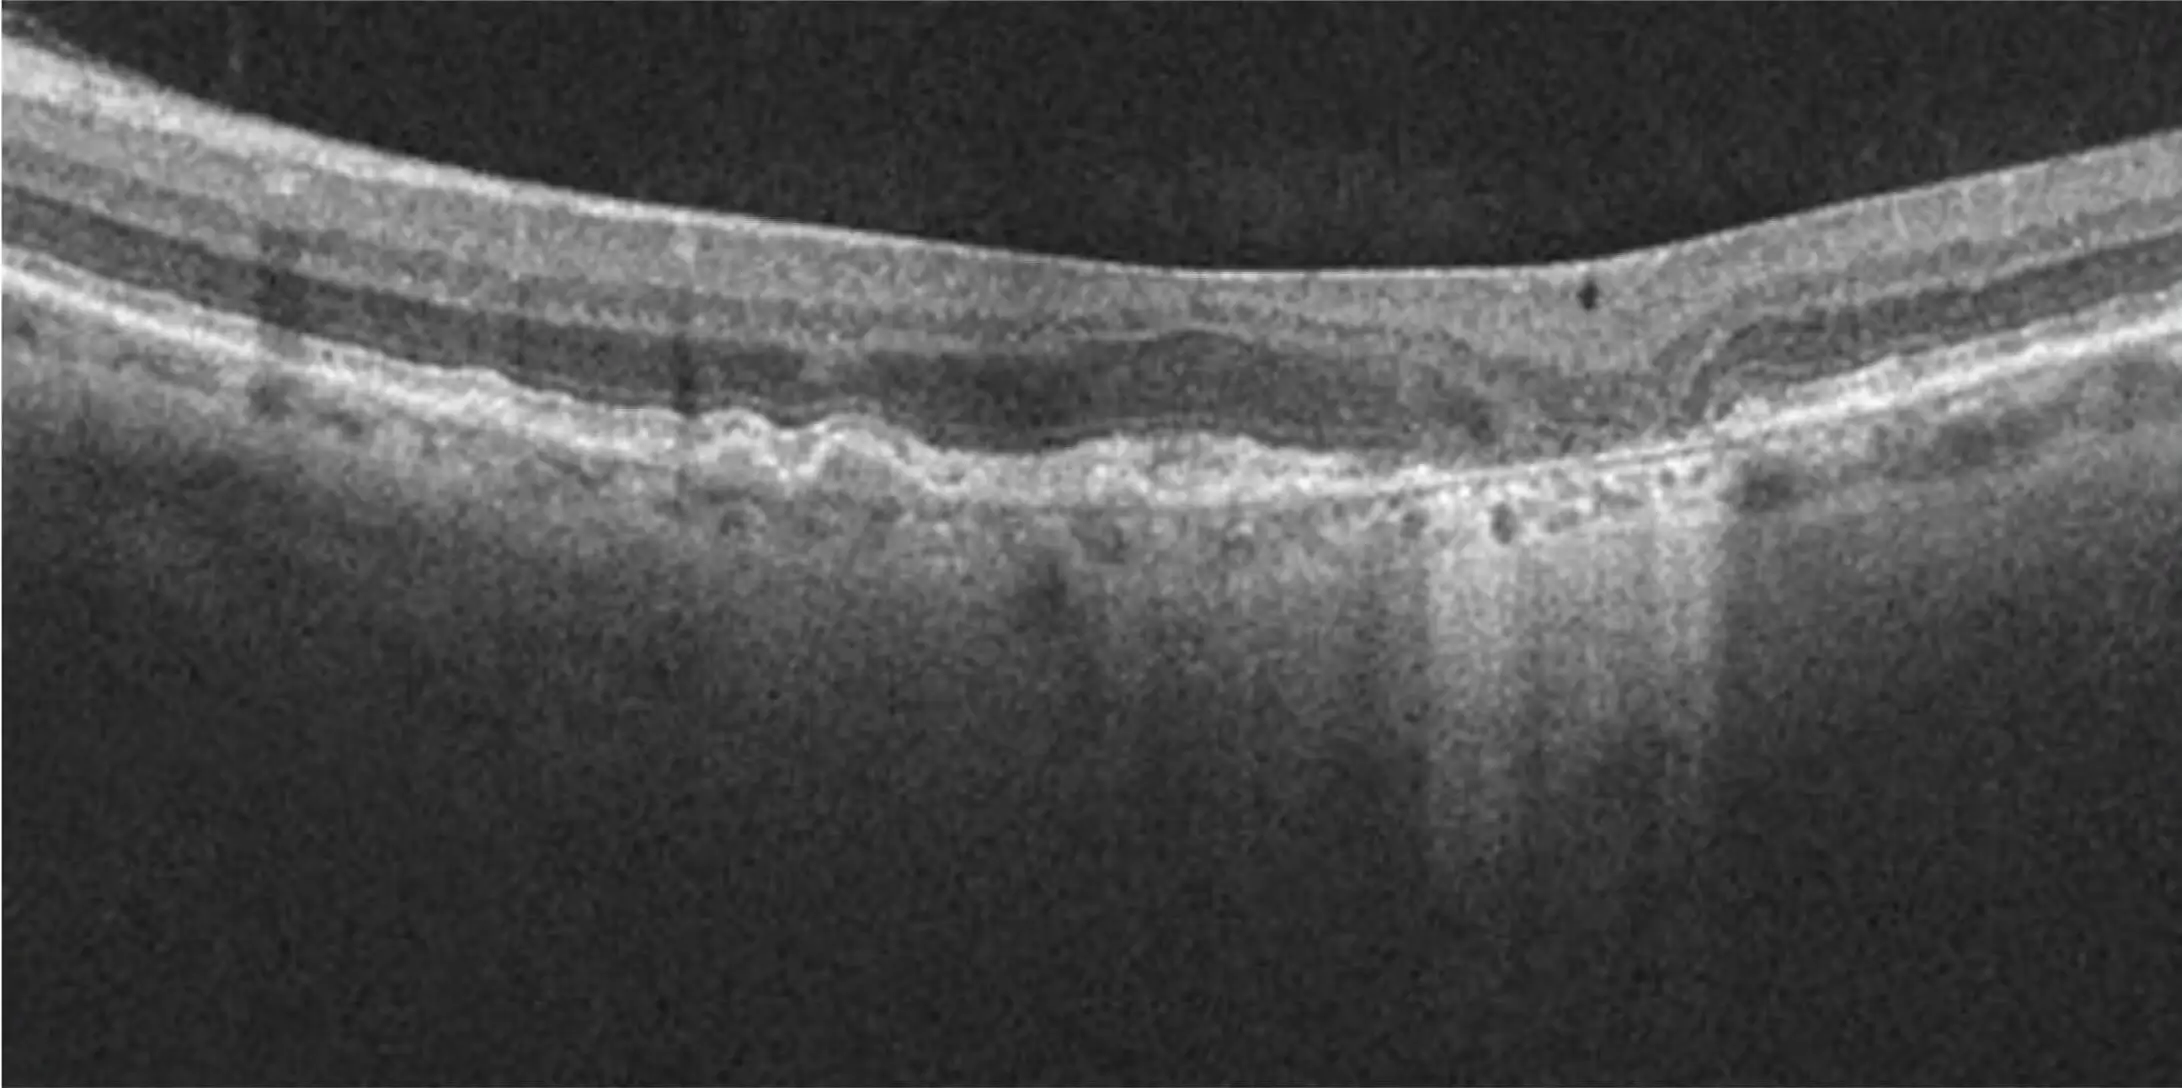

CONTRAINDICATIONS
IZERVAY is contraindicated in patients with ocular or periocular infections and in patients with active intraocular inflammation.
WARNINGS AND PRECAUTIONS
Endophthalmitis and Retinal Detachments
- Intravitreal injections, including those with IZERVAY, may be associated with endophthalmitis and retinal detachments. Proper aseptic injection technique must always be used when administering IZERVAY in order to minimize the risk of endophthalmitis. Patients should be instructed to report any symptoms suggestive of endophthalmitis or retinal detachment without delay and should be managed appropriately.
Neovascular AMD
- In clinical trials, use of IZERVAY was associated with increased rates of neovascular (wet) AMD or choroidal neovascularization (7% when administered monthly and 4% in the sham group) by Month 12. Over 24 months, the rate of neovascular (wet) AMD or choroidal neovascularization in the GATHER2 trial was 12% in the IZERVAY group and 9% in the sham group. Patients receiving IZERVAY should be monitored for signs of neovascular AMD.
Increase in Intraocular Pressure
- Transient increases in intraocular pressure (IOP) may occur after any intravitreal injection, including with IZERVAY. Perfusion of the optic nerve head should be monitored following the injection and managed appropriately.
ADVERSE REACTIONS
Most common adverse reactions (incidence ≥5%) reported in patients receiving IZERVAY were conjunctival hemorrhage, increased IOP, blurred vision, and neovascular age-related macular degeneration.
INDICATION
IZERVAY™ (avacincaptad pegol intravitreal solution) is indicated for the treatment of geographic atrophy (GA) secondary to age-related macular degeneration (AMD)
Please see full Prescribing Information.